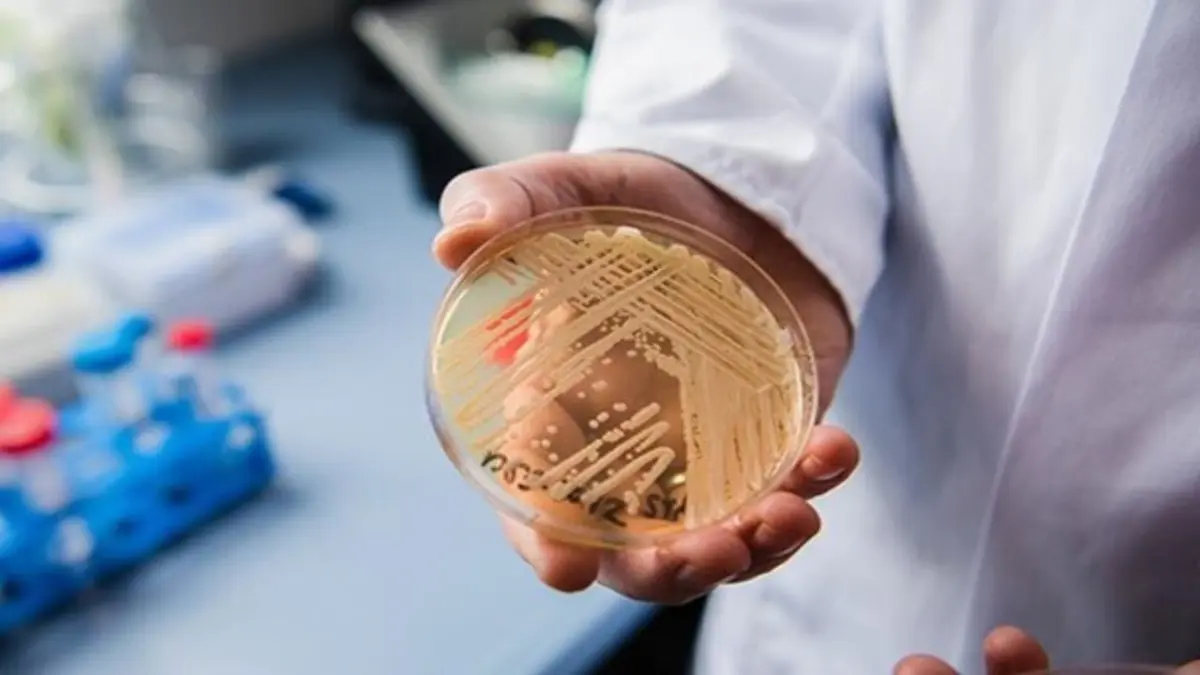
Los científicos alertan ante la amenaza mundial de las enfermedades causadas por hongos

Los científicos alertan ante la amenaza mundial de las enfermedades causadas por hongos
La mayoría de patógenos fúngicos identificados como prioritarios por la Organización Mundial de la Salud (OMS), y que están ligados a cerca de 3,8 millones de muertes al año en todo el mundo, ya son resistentes a los antibióticos o están adquiriendo esas resistencias.
Actualizado: 23 de Julio, 2025, 12:18 AM
Publicado: 13 de Septiembre, 2024, 08:38 AM
Madrid.– MADRID.- Científicos de varios países han alertado de la amenaza que suponen para la humanidad las enfermedades causadas por hongos y de la importancia de impulsar el estudio de este problema, ya que muchos de los patógenos son ya resistentes a los medicamentos.
La mayoría de patógenos fúngicos identificados como prioritarios por la Organización Mundial de la Salud (OMS), y que están ligados a cerca de 3,8 millones de muertes al año en todo el mundo, ya son resistentes a los antibióticos o están adquiriendo esas resistencias.
Para alertar de la gravedad de la amenaza y de la importancia de acelerar el estudio un equipo internacional de investigadores de once países ha publicado hoy una carta en la revista científica The Lancet en la que piden más atención y más recursos para combatir las resistencias a los tratamientos en patologías causadas por hongos.
El artículo está coordinado por el investigador Norman van Rhijn, de la Universidad de Mánchester, y por el profesor Ferry Hagen, del Instituto Westerdijk de Países Bajos, y lo suscriben once científicos de España, Reino Unido, Austria, Turquía, Australia, Uganda, India, Estados Unidos, Brasil, Sudáfrica y China.
Entre las firmantes está la investigadora española del Centro Nacional de Microbiología (CNM) del Instituto de Salud Carlos III (ISCIII) Ana Alastruey, quien coordinó un informe de la OMS sobre patógenos fúngicos que representan un riesgo infeccioso para la salud pública, ha informado este centro en una nota difundida hoy.
Según explican en su artículo los investigadores, la mayoría de los patógenos fúngicos identificados como prioritarios por la Organización Mundial de la Salud (OMS), responsables de alrededor de 3,8 millones de muertes al año en todo el mundo, ya son resistentes o están adquiriendo rápidamente resistencia a los medicamentos antifúngicos.
Argumentan que el enfoque actual, centrado principalmente en las bacterias, no es suficiente para combatir completamente la resistencia a los antimicrobianos, y recuerdan que, a diferencia de las bacterias, las similitudes entre las células fúngicas y las humanas dificultan encontrar tratamientos que inhiban selectivamente los hongos sin causar toxicidad en los pacientes.
Ana Alastruey ha subrayado en la nota difundida hoy por el ISCIII que “la resistencia es más la norma que la excepción en las cuatro clases de antifúngicos disponibles parar tratar infecciones por hongos, lo que dificulta, e incluso imposibilita, el tratamiento de muchas infecciones fúngicas invasivas”.
Las infecciones resistentes a los fungicidas incluyen algunas como "Aspergillus", "Candida" o "Trichophyton indotineae", y cualquiera de ellas puede tener impactos muy relevantes en la salud de personas mayores o en pacientes vulnerables.
En el texto, los firmantes recomiendan un acuerdo mundial para restringir el uso de ciertas clases de moléculas antifúngicas para aplicaciones específicas; una mayor colaboración en soluciones y regulaciones que garanticen la seguridad alimentaria y la salud universal para animales, plantas y seres humanos; y la inclusión de la resistencia a antifúngicos en la reunión de la ONU sobre resistencia a los antimicrobianos que se celebra este mes.
Los investigadores han constatado que, a pesar de las enormes dificultades para desarrollar medicamentos contra infecciones causadas por hongos, en los últimos años han entrado en ensayos clínicos varios agentes nuevos y prometedores, incluidos clases completamente nuevas de moléculas.
Pero han observado que incluso antes de que lleguen al mercado tras años de desarrollo, la industria agroquímica ya ha desarrollado fungicidas con modos de acción similares, lo que provoca resistencias cruzadas que hacen a los científicos retroceder al punto de partida.
Muchos cultivos esenciales se ven afectados por hongos, por lo que la protección antifúngica es necesaria para la seguridad alimentaria, pero los investigadores que firman en The Lancet alertan del alto precio que eso supone para la salud pública.

Agencia EFE
La Agencia EFE, o simplemente EFE, es una agencia de noticias internacional con sede en Madrid. Fue fundada en 1939 gracias al impulso del entonces ministro del Interior, Ramón Serrano Suñer, en la que participaron activamente: José Antonio Jiménez Arnau, Manuel Aznar Zubigaray y Vicente Gállego.
Biografía completa »